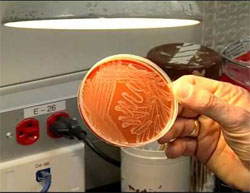

Noi dovezi ale faptului că aşa-zişii «Iluminaţi» se folosesc masiv de ştiinţa biologiei şi a geneticii pentru a reduce populaţia globului (II)
Redactarea finală a textului a fost realizată de profesor yoga Gregorian Bivolaru
Citiți prima parte a articolului
Vaccinarea este actualmente folosită de agenții aşa-zişilor „iluminați” ca o armă biologică
 Laboratoarele americane pentru dezvoltarea de arme biologice se află, se pare, la originea epidemiei de Ebola.
Laboratoarele americane pentru dezvoltarea de arme biologice se află, se pare, la originea epidemiei de Ebola.
Profesorul american de drept Francis A. Boyle a dezvăluit într-un interviu dat în luna octombrie 2014 că Administraţia Statelor Unite s-a folosit de zona Africii de vest pentru a evita respectarea Convenţiei pentru arme biologice şi pentru a pune la cale în mod subversiv acţiuni ale unui război biologic.
Vom prezenta în continuare pasaje din interviul lui Francis Boyle, un cunoscător al dedesubturilor războiului biologic, autor a numeroase lucrări cu privire la subiectul armelor biologice americane, între care menționăm și cartea Biowarfare and Terrorism (Războiul biologic și terorismul). Francis Boyle este un profesor de renume mondial în domeniul său, și anume dreptul internațional. El a conceput legea antiterorism din 1989 cu privire la armele biochimice, legislația americană fiind raliată la Convenția cu privire la armele biologice din 1972. Posesor a două titluri de doctorat obţinute la Universitatea Harvard, unul în drept (încheiat cu Magna cum laude) și unul în științe politice, Boyle predă în prezent la Universitatea Illinois de la Urbana Champaigne.
Francis Boyle a făcut dezvăluiri terifiante cu referire la epidemia de Ebola din Africa de Vest. Părerea lui este că acest caz este sinistru. Cu ceva timp înainte, dăduse un interviu pe un canal grecesc, interviu destul de șocant, în care afirma că această epidemie nu este absolut deloc ceea ce se spune și că toată povestea cu liliecii care ar fi venit pe calea aerului tocmai din Zair pentru a aduce boala, respectiv o variantă a ei, aşa numita „Ebola din Zair”, este foarte ciudată, mai ales pentru că Zairul se află la distanță de mai bine de 3.500 de kilometri de zonele respective. Așadar, despre ce este vorba?
În opinia lui Boyle: „Între noi fie vorba, toată această poveste este cusută cu ață albă. Guvernul american deține trei laboratoare BSL4 (bio safety lab nivelul patru), unul în Guineea, unul în Liberia, unul în Sierra Leone, chiar în inima epidemiei, în Africa de vest. În laboratoarele BSL4 se fac tot felul de cercetări dintre cele mai înspăimântătoare cu privire la armele biologice”. Aceste unități de cercetare au fost amplasate în Guineea deoarece această ţară nu a semnat Convenția cu privire la armele biologice. Și nici Liberia. Sierra Leone a semnat-o, însă este colonie britanică. În opinia lui Boyle: „Am contestat încă din 1988 programul de cercetare al Pentagonului cu privire la Apărarea biologică (Biological Defense Program) și puteți citi aceasta în cartea mea. I-am întrebat de ce anume conduc această «dublă cercetare», ofensivă și defensivă, cu privire la armele biologice în Liberia care, la vremea respectivă, se afla sub dictatura militară a Căpitanului Doe, susținut de CIA, nerespectând în felul acesta Convenția cu privire la armele biologice. Am totul aici, într-un document al guvernului american intitulat «Biological Defense Program», și veți găsi toate acestea în cartea mea. În cadrul Centrului pentru Controlul Bolilor (Center for Desease Control, prescurtat CDC) se efectuau cercetări în domeniul biologic pentru Pentagon în Sierra Leone încă din anul 1988 și probabil chiar înainte de această dată, întrucât la momentul respectiv laboratorul exista deja. În plus, Columbia University realiza, de asemenea, studii în domeniul armelor biologice (Bio Warfare) pentru Pentagon în Liberia tot din anul 1988. Acesta este laboratorul pe care l-am contestat referitor la încălcarea termenilor Convenției cu privire la armele biologice (BWC BioWeapons Convention).
 După cum vedeți, totul nu este decât o vastă operațiune sub acoperire realizată chiar de CDC. Am studiat amănunțit aceste aspecte și am constatat că se fac eforturi imense de cercetare cu privire la armele biologice cel puțin din anul 1988.” Pentru a putea justifica aceste studii înspăimântătoare, dacă citiți contractele, o să găsiți: „Ar putea să apară această teribilă formă de boală și trebuie să dezvoltăm un vaccin pentru aceasta. Așadar vom începe prin a lucra asupra acestui virus și va fi probabil necesar să-l modificăm genetic”.
După cum vedeți, totul nu este decât o vastă operațiune sub acoperire realizată chiar de CDC. Am studiat amănunțit aceste aspecte și am constatat că se fac eforturi imense de cercetare cu privire la armele biologice cel puțin din anul 1988.” Pentru a putea justifica aceste studii înspăimântătoare, dacă citiți contractele, o să găsiți: „Ar putea să apară această teribilă formă de boală și trebuie să dezvoltăm un vaccin pentru aceasta. Așadar vom începe prin a lucra asupra acestui virus și va fi probabil necesar să-l modificăm genetic”.
Boyle ne dă și alte indicații: „La începutul anilor 1980, sub administrația Reagan, în momentul în care am luat la cunoștință toate aceste elemente legate de posibilele modificări genetice, am fost șocat că intenționau să facă o asemenea oroare pentru a crea un vaccin care să protejeze, zice-se, populația. Toate acesta erau scrie negru pe alb și ei făceau aceasta cu toți virușii: Ebola, febra hemoragică etc. Dacă nu mă credeți, puteți citi chiar într-o ediție a cotidianului New York Times cum administrația Obama a căutat să îngroape toate aceste elemente într-un morman de informații. Obama afirmă: «Politica noastră oficială este de acum înainte aceea de a opri acest gen de cercetare». Ceea ce înseamnă că ei recunosc că fac aceasta, iar dacă aruncați o privire pe lista acestor cercetări care vor fi oprite, nu veți găsi virusul Ebola. De ce? Acesta înseamnă că ei nu făceau o «dublă cercetare» pe Ebola. Toate aceste informații sunt publice. Dacă Ebola ar fi fost pe lista articolului, acești oameni ar fi întrebat: dar ce faceți cu acest virus Ebola? Acest articol este într-un fel acel «smoking gun» (pistolul fumegând, dovada irefutabilă), întrucât Obama admite că Statele Unite au realizat acest gen de cercetări.
Consultând documentația, am putut să ajung până la administrația Reagan, cu acei neoconservatori care au ajuns la putere și care doreau arme biologice. Puteți, de asemenea, să citiți documentul Proiectul Pentru un Nou Secol American (Project for the New American Century, prescurtat PNAC) din anul 2002, când acești neoconservatori din epoca Reagan scriau negru pe alb că doresc să dezvolte arme biologice.
 Au revenit la putere cu Bush junior și au continuat să-şi pună în aplicare intențiile. Neoconservatorii doreau aceste arme biologice și cred că într-adevăr aceste proiecte au început în timpul lui Reagan și că au continuat după aceea. A doua administrație Reagan nu a făcut decât să le continue, cel mai sigur sub influența lui Richard Danzing, care este acum în Consiliul de Administrație al acestor societăți «Big Pharma» și care a stabilit acorduri încălcând Foreign Exchange Act.
Au revenit la putere cu Bush junior și au continuat să-şi pună în aplicare intențiile. Neoconservatorii doreau aceste arme biologice și cred că într-adevăr aceste proiecte au început în timpul lui Reagan și că au continuat după aceea. A doua administrație Reagan nu a făcut decât să le continue, cel mai sigur sub influența lui Richard Danzing, care este acum în Consiliul de Administrație al acestor societăți «Big Pharma» și care a stabilit acorduri încălcând Foreign Exchange Act.
Toate epidemiile de Ebola care s-au declanşat în Africa înainte fuseseră circumscrise cu o rată de mortalitate de 50%. Această epidemie nouă nu este circumscrisă și are o rată de 70%. Toate aceste date mă fac să concluzionez că avem de-a face cu un organism modificat genetic, adică cu un OMG. Știm că acest tip de studii a fost realizat la Fort Detrick. Mai este, de asemenea, și acel Doctor Kawaoka de la Universitatea din Wisconsin, din Madison, care a recunoscut pe pagina sa web că a modificat genetic virusul Ebola pentru a-l face mai agresiv. De asemenea, acesta a resuscitat virusul gripei spaniole în cadrul unui proiect demarat de Pentagon. El a făcut cercetări foarte avansate cu privire la gripă, inclusiv modificând genetic virusul H5N1, acest virus al gripei atât de periculos care a făcut ravagii cu ocazia epidemiei de SARS (SRAS – sindromul respirator acut sever) și totul a fost finanțat de către Pentagon, de către National Institute of Health (NIH) sau de către CDC. Aceste studii erau atât de periculoase, încât a trebuit să își transfere laboratorul din Wisconsin în Winnipeg, însă probabil că autoritățile canadiene au spus: «Plecați de aici, n-avem nevoie de voi, este prea periculos pentru noi». Nu știu. Ceea ce se știe însă este că laboratorul BSL4 Kanema din cadrul Universității din Tulane a fost implicat. Știm că ei fac acest gen de cercetare asupra armelor biologice de foarte mult timp.
Laboratorul US de la Fort Detrick era implicat, de asemenea. Se ştie că realizează acest gen de cercetare de mult timp, inclusiv asupra virusului Ebola. Cele trei laboratoare pe care le-am citat au fost, toate, instituite de către USAID, care nu este altceva decât o organizație care servește drept paravan pentru CIA. Caut doar să leg toate aceste puncte între ele pe baza informațiilor pe care le-am putut aduna de mult timp cu privire la aceste arme biologice, încă de pe vremea studiilor mele la Universitatea de drept din Harvard și sunt interesat profesional de această chestiune, întrucât am fost chemat să fiu apărătorul Consiliului pentru o Genetică Responsabilă (Council for Responsible Genetics) la începutul anilor 1980, în Comitetul lor asupra armelor biologice”.
 Ne putem acum întreba dacă această epidemie a fost declanșată în mod deliberat ori dacă este vorba despre un accident, virusul scăpând din laborator fără voia savanților? În opinia lui Boyle: „Dacă mergeți pe site-ul web al Ministerului Sănătății din Sierra Leone, deci este vorba despre o informație publică, veți vedea că au închis BSL4 din Kanema în vara aceasta și au afirmat că acest laborator era sursa epidemiei Ebola, iar că Tulane și alte laboratoare administrau aceste vaccinuri oamenilor. Spun că este vorba despre un vaccin, însă în realitate este vorba chiar de virusul Ebola viu. Deci pentru așa-zisul vaccin, ei lucrează cu virusul Ebola viu. În plus, știm că NIH a lucrat cu CDC de ceva timp încoace pentru a combina virusul viu al Ebola cu cel al răcelii comune. Și, așadar, dacă puneți împreună virusul Ebola viu cu cel al răcelii, veți obține ceva care este la fel de contagios ca răceala comună, dar nu la fel de contagios ca și gripa. Cred că avem de-a face acum exact cu aceasta. Acest vaccin, sau numiţi-l cum doriți, care include virusul Ebola viu și virusul răcelii comune a fost injectat unei vaste populații din Sierra Leone și probabil chiar și în Liberia, iar aceasta este la originea epidemiei. Însă nu trebuie să mă credeți pe cuvânt, puteţi verifica voi înşivă. Vizitaţi site-ul web al Ministerului Sănătății din Sierra Leone și veți vedea că aceasta este concluzia lor cu privire la ce se petrece în prezent. Acesta este motivul pentru care au luat măsura închiderii laboratorului american BSL4 în vara aceasta.”
Ne putem acum întreba dacă această epidemie a fost declanșată în mod deliberat ori dacă este vorba despre un accident, virusul scăpând din laborator fără voia savanților? În opinia lui Boyle: „Dacă mergeți pe site-ul web al Ministerului Sănătății din Sierra Leone, deci este vorba despre o informație publică, veți vedea că au închis BSL4 din Kanema în vara aceasta și au afirmat că acest laborator era sursa epidemiei Ebola, iar că Tulane și alte laboratoare administrau aceste vaccinuri oamenilor. Spun că este vorba despre un vaccin, însă în realitate este vorba chiar de virusul Ebola viu. Deci pentru așa-zisul vaccin, ei lucrează cu virusul Ebola viu. În plus, știm că NIH a lucrat cu CDC de ceva timp încoace pentru a combina virusul viu al Ebola cu cel al răcelii comune. Și, așadar, dacă puneți împreună virusul Ebola viu cu cel al răcelii, veți obține ceva care este la fel de contagios ca răceala comună, dar nu la fel de contagios ca și gripa. Cred că avem de-a face acum exact cu aceasta. Acest vaccin, sau numiţi-l cum doriți, care include virusul Ebola viu și virusul răcelii comune a fost injectat unei vaste populații din Sierra Leone și probabil chiar și în Liberia, iar aceasta este la originea epidemiei. Însă nu trebuie să mă credeți pe cuvânt, puteţi verifica voi înşivă. Vizitaţi site-ul web al Ministerului Sănătății din Sierra Leone și veți vedea că aceasta este concluzia lor cu privire la ce se petrece în prezent. Acesta este motivul pentru care au luat măsura închiderii laboratorului american BSL4 în vara aceasta.”
Așadar de ce nu a tras nimeni niciun semnal de alarmă cu privire la acest subiect? În opinia lui Boyle: „Dacă priviți ceea ce s-a petrecut dea lungul tuturor acestor ani, iar aceste informații, vă reamintesc, sunt informații publice, veți vedea că cel puțin 27 microbiologi au murit în condiții suspecte. Cred că cercetătorii intenționau să dezvăluie anumite aspecte cu privire la aceste programe care, nu numai că sunt periculoase, dar sunt și ilegale. Așadar, toți acești specialiști au fost uciși și acesta este motivul pentru care nu avem specialiști care să dea alarma, iar cei care sunt în continuare în viață tac din teama de a nu fi, la rândul lor, uciși. Cred că faptele sunt clare. Cred, de asemenea, că toți acești specialiști în microbiologie, în loc să tragă semnalul de alarmă în public, au mers să discute cu superiorii lor la CDC sau în altă parte. Aceste informații şi-au urmat calea, iar oamenii au fost eliminați. Acesta este motivul pentru care nu avem oameni care să ne atenționeze sau, mai bine zis, am avut, dar acum sunt toți morți înainte ca să fi putut spune ceva.”
De ce mor pe capete ‒ în condiţii suspecte ‒ specialiștii în microbiologie?
 Discuțiile cu privire la originea virusului Ebola s-au amplificat în urma morții „accidentale”, în iulie anul trecut, a specialistului mondial în acest virus, pe numele său Glenn Thomas, și a numeroși alți specialiști în microbiologie în catastrofa zborului MH17 din Ucraina.
Discuțiile cu privire la originea virusului Ebola s-au amplificat în urma morții „accidentale”, în iulie anul trecut, a specialistului mondial în acest virus, pe numele său Glenn Thomas, și a numeroși alți specialiști în microbiologie în catastrofa zborului MH17 din Ucraina.
Toate acestea ne amintesc de un capitol îngrijorător și foarte bine documentat din cartea scriitorului italian Roberto Quaglia, Il Mito del 11 settembre e l’opzione Dottore Stranamore, apărută în 2007 și care a fost tradusă în limba română sub titlul 11 septembrie. Mitul. Culisele unei crize programate, în anul 2009, la Editura Ștefan. Autorul scria la scurt timp după epidemia SARS, care a făcut ravagii între noiembrie 2002 și mai 2003, afectând numeroase țări, și la aproximativ un an după scrisorile cu antrax din octombrie 2001. Între 12 noiembrie 2001 și 11 februarie 2002, șapte specialiști de rang înalt în microbiologie, cunoscuți la nivel internațional, au murit. Nu toți microbiologii se află în aceeași zonă de risc, însă specialiștii în secvențele de ADN par să fie cei mai susceptibili de a muri în circumstanțe „suspecte și neobișnuite”. Analiza succesiunii secvențelor de ADN este una dintre tehnicile necesare cercetărilor emergente cu privire la aplicarea armelor biologice de distrugere în masă, în special în ceea ce privește crearea unor noi virusuri și a unor noi bacterii. Meseria de microbiolog pare chiar să fi devenit o activitate riscantă după atentatele de la 11 septembrie 2001.
De exemplu, pe 4 octombrie 2001, un avion comercial care făcea legătura între Israel și Novosibirsk a fost doborât „din greșeală” deasupra Mării Negre de către o rachetă trasă la mai bine de o sută de kilometri distanță de o zonă în care aveau loc exercițiile militare, care se pare că abia începuseră. Inițial s-a spus că era vorba despre un zbor care transporta mărfuri, însă de fapt era vorba de un zbor de linie și anume Air Sibir 1812. Novosibirsk este cunoscut ca fiind capitala științifică a Siberiei și este totodată recunoscut ca fiind sediul unor importante cercetări în microbiologie. „Întâmplarea” a făcut ca la bordul avionului să fie cel puțin cinci microbiologi israelieni.
Pe 12 noiembrie 2001, Benito Que, în vârstă de 52 de ani, expert în boli infecțioase și în biologie celulară, a fost găsit prăbuşit, în comă, pe o stradă din apropierea laboratorului Universității Medicale din Miami, unde acesta lucra. Neoficial s-a afirmat că a fost agresat de către patru persoane înarmate cu bâte de baseball, însă versiunea oficială susţine că el a fost victima unei stări de rău care s-a declanșat în plină stradă. Benito Que a murit pe 6 decembrie 2001. El era un expert în analiza secvențelor de ADN. Lucrase cu Don C. Wiley și cu David Kelly, alți doi microbiologi care şi-au găsit sfârșitul în condiții mai mult decât suspecte.
Pe 15 noiembrie 2001, Don C. Wiley, în vârstă de 57 de ani, unul dintre principalii experți americani în domeniu, a dispărut. Mașina pe care-o închiriase a fost găsită abandonată pe podul Hermando de Sotto, în apropiere de Memphis, cu rezervorul plin și cu cheile în contact. Wiley tocmai luase cina și urma foarte curând să plece în vacanță cu familia. Trupul neînsuflețit a fost găsit pe 20 decembrie, în Mississippi, la 50 kilometri distanță de locul în care a fost găsită mașina. Explicația oficială a fost că, fiind cuprins de amețeală, acesta ar fi căzut de pe pod. Wiley era specialist în domeniul răspunsului sistemului imunitar la atacurile virale cum ar fi SIDA, Ebola sau gripa. Acesta primise un foarte prestigios premiu pentru întreaga sa activitate în domeniul vaccinurilor antivirale. Wiley se ocupa și el de analiza secvențelor de ADN și colaborase cu David Kelly.
 Pe 23 noiembrie 2001, Vladimir Paseșnik, în vârstă de 64 de ani, biolog specializat în ciuma bubonică, a fost găsit mort la Wishire, în Anglia, nu departe de locuința sa. Acesta fusese implicat în dezvoltarea armelor biologice în Uniunea sovietică și fugise în Vest la începutul anilor 1990. A doua zi, pe 24 noiembrie 2001, un avion Crossair s-a prăbușit în Elveția. Printre pasagerii care se aflau la bord erau și trei eminenți cercetători de origine israeliană: Yakov Matzer, în vârstă de 54 de ani, președinte al Departamentului de medicină din cadrul Universității Evreiești, Amiramp Eldor, în vârstă de 59 de ani, șef al Departamentului de hematologie din cadrul Spitalului din TelAviv, și Avishai Berkman, în vârstă de 50 de ani, director al Departamentului de Sănătate publică din TelAviv.
Pe 23 noiembrie 2001, Vladimir Paseșnik, în vârstă de 64 de ani, biolog specializat în ciuma bubonică, a fost găsit mort la Wishire, în Anglia, nu departe de locuința sa. Acesta fusese implicat în dezvoltarea armelor biologice în Uniunea sovietică și fugise în Vest la începutul anilor 1990. A doua zi, pe 24 noiembrie 2001, un avion Crossair s-a prăbușit în Elveția. Printre pasagerii care se aflau la bord erau și trei eminenți cercetători de origine israeliană: Yakov Matzer, în vârstă de 54 de ani, președinte al Departamentului de medicină din cadrul Universității Evreiești, Amiramp Eldor, în vârstă de 59 de ani, șef al Departamentului de hematologie din cadrul Spitalului din TelAviv, și Avishai Berkman, în vârstă de 50 de ani, director al Departamentului de Sănătate publică din TelAviv.
Pe 10 decembrie 2001, Robert Schwartz a fost găsit asasinat în casa lui de la țară, din zona Loudoun, statul Virginia. Pe 11 decembrie 2001, Set Van Naguyen, în vârstă de 44 de ani, a fost găsit mort la intrarea într-o cameră frigorifică din laboratorul în care lucra la Geelong, din statul Victoria, în Australia. Acesta intrase în camera frigorifică fără să-şi dea seama că era plină de un gaz otrăvitor care l-a ucis rapid. În același centru de cercetări, cu cinci ani în urmă, fusese izolat un virus din familia Paramyxoviridae care are o rădăcină comună cu virusul SARS. Acest gen de virus fusese identificat.
Microbiologii de vârf specializaţi în virusologie sunt ucişi pe capete. Doar în anul 2005, au murit peste 20. Astăzi, sunt peste 100 de cazuri. Mulţi au fost ucişi, restul au murit în circumstanţe stranii. Se ştie însă că toţi lucrau la cercetări extrem de valoroase sau la proiecte de cercetare finanţate de guvern care erau legate fie de producerea unor arme biologice, fie de crearea în laborator a unor virusuri mortale. Mass-media nu a suflat un cuvinţel despre toate aceste cazuri suspecte şi multiple ca fiind transmisibil la ființele umane.
Pe 9 noiembrie 2002, Victor Korshunov, în vârstă de 56 de ani, director la subfacultatea de microbiologie din cadrul Universității de Stat din Moscova, a fost găsit mort pe stradă. Doi alți cercetători ruși, Ivan Glebov și Alexi Brushlinski, au fost uciși în cursul săptămânilor următoare. Pe 11 februarie 2002, Ian Langford, în vârstă de 40 de ani a fost găsit mort în reședința sa din Norwich, Anglia.
Pe 27 februarie, Tanya Holzmayor, în vârstă de 46 de ani, cercetătoare rusă emigrată în Statele Unite, a murit în urma unei împușcături. Presupusul autor a fost un alt microbiolog, Guyang Huang, care a fost găsit și el mort ceva mai târziu, într-un parc, cu pistolul nu departe de mâna sa. Tanya Holzmayor se ocupa de genomul uman.
David WynnWilliams, în vârstă de 55 de ani, astrobiolog implicat în cercetarea cu privire la eventuala existență a microbilor extratereștri, a murit pe 24 martie, lovit de o mașină în timp ce făcea jogging.
David WynnWilliams, în vârstă de 55 de ani, astrobiolog implicat în cercetarea cu privire la eventuala existență a microbilor extratereștri, a murit pe 24 martie, lovit de o mașină în timp ce făcea jogging.
Steven Mostow, în vârstă de 63 de ani, cunoscut ca „Doctor Gripă” datorită experienței sale în tratarea acestei boli, a murit într-un „accident” al avionului personal Cessna, în etapa de aterizare, când se pare că unul dintre cele două motoare s-ar fi desprins. Acesta era, de asemenea, cunoscut ca fiind un expert în bioterorism.
Pe 24 iunie 2003, doctorul Leland Rickman, în vârstă de 47 de ani, a murit ca urmare a unei presupuse boli. Acesta era expert în boli infecțioase și lucra, de asemenea, ca și consultant în materie de bioterorism.
Pe 17 iulie, trupul neînsuflețit a lui David Kelly, în vârstă de 59 de ani, expert în microbiologie, dar și consultant pentru guvernul britanic în materie de arme biologice de distrugere în masă, a fost găsit într-o pădure. Ancheta a concluzionat că a fost vorba de sinucidere, însă toate dovezile indică, dimpotrivă, că David Kelly a fost victima unui asasinat. Câteva luni mai târziu, conform mărturiilor, s-a aflat că David Kelly intenționa să scrie o carte despre programele de război biologic ale marilor state. Trebuie să adăugăm la această listă și cazul lui Jeffrey Paris, în vârstă de 49 de ani, găsit lovit într-o parcare, pe 6 noiembrie 2001, dar și cazul lui Christopher Legallo, în vârstă de 33 de ani, analist specializat în probleme de terorism, avionul în care se afla, prăbuşindu-se pe 30 septembrie 2002. La bordul aceluiași avion ar fi trebuit să se afle și soția sa, Laura Koephler, analistă în domeniul armelor de distrugere în masă, însă aceasta și-a anulat zborul în ultimul moment, datorită unei schimbări de program.
Seria deceselor ciudate ale microbiologilor a continuat și după aceea. În opinia lui Maurizio Blondet (La Strage dei genetisti – Masacrul geneticienilor), până în iunie 2004 numărul total al microbiologilor care au murit în circumstanțe suspecte a urcat la 24. Este greu de presupus că moartea tuturor acestor specialiști în microbiologie este o anomalie statistică. Până la a doua ediție a cărții lui Blondet, în 2007, s-au mai înregistrat câteva zeci de dispariții suspecte ale unor mari specialiști din domeniu.
 De exemplu, John Clark, un microbiolog ale cărui cercetări au condus la clonarea faimoasei oi Dolly, s-a spânzurat pe 12 august 2004.
De exemplu, John Clark, un microbiolog ale cărui cercetări au condus la clonarea faimoasei oi Dolly, s-a spânzurat pe 12 august 2004.
Leonid Strachonsky, specialist în crearea microbilor rezistenți la armele biologice, a murit pe 8 iunie 2005, din cauza unei sticle de șampanie care, în loc să i se urce la cap, i s-a spart în cap.
David Banks, expert în prevenția epidemiilor și în măsuri de carantină, a murit pe 8 mai 2005 la bordul unui avion care s-a prăbușit conform scenariului clasic.
Matthew Allisson, specialist în biologie moleculară, s-a urcat pe 13 octombrie 2004 la bordul mașinii personale, care a explodat așa cum se petrece numai în filme.
Vom încheia această listă cu Antonina Presnyakova, o cercetătoare care se ocupa în mod direct de armele biologice și care, pe 25 mai 2004, a trăit la rândul său scene demne de un film de groază, înţepându-se din greșeală cu un ac infectat cu virusul Ebola. Presnyakova a murit la scurt timp după aceea. Nu este prima dată când oameni de știință specializați într-un anumit sector de importanță capitală mor la scurt timp unul după celălalt și în condiții misterioase. Ne putem pune întrebarea: cine se află în spatele acestor crime și cine profită de pe urma lor?
Vaccinurile Gardasil și Cervarix nu numai că nu imunizează împotriva cancerului de col uterin, ci sunt extrem de dăunătoare (uneori chiar mortale) pentru sănătate
Anunțul punerii pe piață a unui nou vaccin împotriva cancerului cervical ne îndeamnă să punem în discuție un iminent scandal sanitar care a urmat și în care sunt implicate milioane de tinere.
Într-o lume în care nimic nu mai este privit cu sfințenie, am putea să cerem ca măcar sângele copiilor noștri să înceteze să mai fie supus capriciilor extravagante ale politicienilor și ale marilor companii farmaceutice. După cum am amintit, accidentele, sechelele și plângerile victimelor care s-au vaccinat sunt din ce în ce mai numeroase, iar ca exemplu, utilitatea vaccinurilor Gardasil și Cervarix nu a putut fi încă demonstrată. Deși cancerul de col uterin nu este o problemă de sănătate publică, aceste vaccinuri sunt rambursate de către serviciile de asigurări medicale, în ciuda prețului lor exorbitant, fiind chiar recomandate de… politicieni. Toate acestea se petrec în detrimentul unei măsuri preventive care și-a dovedit întreaga eficiență, și anume depistarea cu ajutorul frotiului cervical.
 Odată cu noul vaccin, operațiunea va lua un nou avânt în perioada următoare și va face să fie dat uitării bilanțul tragic al vaccinurilor precedente, țintind de data aceasta către un public din ce în ce mai larg și mai tânăr. Așadar, ce ar trebui să denunțăm mai întâi: aceste noi „produse de sănătate”, reînnoite la infinit, ori deriva politică, administrativă și medicală ce contribuie la superprofiturile unei industrii farmaceutice care se află în mâinile marilor bancheri internaţionali, în detrimentul sănătății popoarelor?
Odată cu noul vaccin, operațiunea va lua un nou avânt în perioada următoare și va face să fie dat uitării bilanțul tragic al vaccinurilor precedente, țintind de data aceasta către un public din ce în ce mai larg și mai tânăr. Așadar, ce ar trebui să denunțăm mai întâi: aceste noi „produse de sănătate”, reînnoite la infinit, ori deriva politică, administrativă și medicală ce contribuie la superprofiturile unei industrii farmaceutice care se află în mâinile marilor bancheri internaţionali, în detrimentul sănătății popoarelor?
Presiunile făcute pentru ca adolescentele să fie vaccinate împotriva cancerului de col uterin sunt foarte puternice. Cei curioși să se documenteze chiar și pe internet cu privire la cazuistica îmbolnăvirilor în urma vaccinării vor găsi o mulțime de mărturii cutremurătoare semnate de o mulţime de femei: Lena, Kelly, Laura, Sara, Melania, Iulia, Matilda, Jennifer, Maria… Aceste nume reprezintă tot atâtea fete și tinere femei care ar fi putut fi rudele noastre, tinere debordând de sănătate, cu o mulțime de planuri de viitor, cu poftă de viață, tinere care însă au pierdut totul între 14 și 18 ani și care, pentru tot restul vieții lor, vor trebui să se ocupe de simptomele îmbolnăvirii care s-a produs ca urmare a vaccinării împotriva cancerului de col uterin.
Din fericire, aceste tinere femei care şi-au publicat mărturiile și relatările pe site-ul lesfillesetlegardasil.com (Fetele și Gardasilul) sunt în continuare printre noi; lista celor care chiar au murit ca urmare a vaccinării cu Gardasil este încă și mai numeroasă. Pentru a ne convinge, este suficient să accesăm pagina web Gardasil și fetele aflate în pericol sau site-ul sanevax.org, unde se află memorialul victimelor. Aceste mărturii nu cad în capcana dramatismului ieftin: există fotografii ale tinerelor înainte să fie atinse de boală, în splendoarea tinereții lor, iar mărturiile coborârii lor în infern rămân pline de demnitate. Deși aspectul uman trebuie să rămână în centrul preocupărilor, totuși este important ca într-o astfel de analiză să nu ne lăsăm ghidați doar de elementele pur emoționale şi să trecem şi la cifre.
Decese multiple și unele handicapuri
Doar în Statele Unite, cel puțin 37.920 de femei au semnalat efecte secundare nefaste ale injectării vaccinurilor Gardasil și Cervarix, grație sistemului de farmacovigilență american. O treime dintre aceste femei au fost spitalizate în regim de urgență, iar 20% nu şi-au mai putut reveni la o stare de sănătate satisfăcătoare. Cu toate acestea, campania de vaccinare continuă să se desfășoare în SUA, țară care a fost și rămâne una dintre primele promotoare ale vaccinului, alături de Australia și de Canada.
Numărul de decese declarate la sfârșitul anului 2014 ca urmare a acestor vaccinuri s-a ridicat la 216 cazuri. Mai bine de 1.000 de femei au rămas cu handicap grav. Știind că, raportat la cazurile reale, efectele secundare semnalate nu sunt decât vârful aisbergului, ne putem imagina amploarea dezastrului sanitar la care asistăm.
 „Deși nu putem verifica, este necesar să multiplicăm cifrele oficiale cu 10 pentru a avea astfel o reprezentare mai apropiată de realitatea situației. Este interesant, de asemenea, să extrapolăm datele americane la situația generală, întrucât dispozitivul american de farmacovigilență este considerat de către mulți experți independenți ca fiind mai eficient”, afirmă doctorul Gérard Delépine, celebru chirurg și oncolog francez, care a publicat împreună cu soția sa, dr. Nicole Delépine, mai multe articole de avertisment cu privire la această campanie criminală de vaccinare în masă.
„Deși nu putem verifica, este necesar să multiplicăm cifrele oficiale cu 10 pentru a avea astfel o reprezentare mai apropiată de realitatea situației. Este interesant, de asemenea, să extrapolăm datele americane la situația generală, întrucât dispozitivul american de farmacovigilență este considerat de către mulți experți independenți ca fiind mai eficient”, afirmă doctorul Gérard Delépine, celebru chirurg și oncolog francez, care a publicat împreună cu soția sa, dr. Nicole Delépine, mai multe articole de avertisment cu privire la această campanie criminală de vaccinare în masă.
Prezentăm mai jos o listă ce cuprinde efectele secundare nefaste ale vaccinurilor Gardasil și Cervarix, în cifre:
Handicapuri 1.261
Decese 261
Sechele 7.573
Anomalii ale frotiului cervical 595
Displazii cervicale 262
Cancere de col 100
Risc vital 679
Consultații medicale de urgență 12.258
Spitalizări 3.945
Spitalizări prelungite 262
Efecte secundare grave 5.310
Efecte secundare 37.920
Citiți a treia parte a acestui articol
Citiţi şi:
Mai multor copii din România li s-a făcut rău după vaccinare. Medicii spun că totul a fost doar o… halucinaţie!
Bill Gates recunoaşte că vaccinurile sunt folosite pentru reducerea populaţiei la nivel mondial
Gardasil 9: noile manevre ale companiei farmaceutice Merck
yogaesoteric
6 noiembrie 2015
